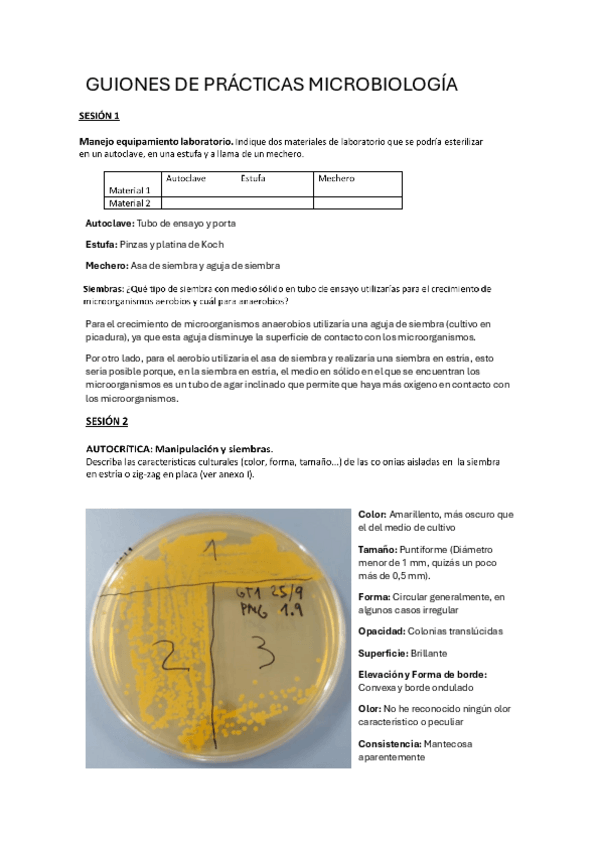

Microbiología
He publicado nuevos apuntes de 2º Microbiología: tabla-clasificaicon-microscopia.pdf
apuntes
-
TODO PARCIAL II
He publicado nuevos apuntes de 2º Microbiología: TODO PARCIAL II
He publicado nuevos ejercicios de 2º Microbiología: EJERCICIOS-MICRO-T3-y-T6.pdf
He publicado nuevos apuntes de 2º Microbiología: Temario-completo-Microbiologia-2024-25-Para-resumir.pdf
He publicado nuevos practicas de 2º Microbiología: PRACTICAS-MICROBIOLOGIA-2024-25.pdf
He publicado nuevos practicas de 2º Microbiología: GUION-PRACTICAS-1-5.pdf
He publicado nuevos apuntes de 2º Microbiología: T3-MICRO.-TECNICAS.pdf
He publicado nuevos apuntes de 2º Microbiología: T1-MICROBIOLOGIA-INTRO.pdf
apuntes
-
PARCIAL 2
He publicado nuevos apuntes de 2º Microbiología: PARCIAL 2
apuntes
-
Apuntes 2ª parte
He publicado nuevos apuntes de 2º Microbiología: Apuntes 2ª parte
trabajos
-
Seminario
He publicado nuevos trabajos de 2º Microbiología: Seminario
apuntes
-
Segundo parcial
He publicado nuevos apuntes de 2º Microbiología: Segundo parcial
apuntes
-
Primer parcial
He publicado nuevos apuntes de 2º Microbiología: Primer parcial
He publicado nuevos practicas de 2º Microbiología: guion-practicas-micro.pdf
apuntes
-
APUNTES MICRO
He publicado nuevos apuntes de 2º Microbiología: APUNTES MICRO
apuntes
-
APUNTES MICRO 2023-24
He publicado nuevos apuntes de 2º Microbiología: APUNTES MICRO 2023-24
apuntes
-
BIOLOGÍA MOLECULAR
He publicado nuevos apuntes de 2º Microbiología: BIOLOGÍA MOLECULAR
apuntes
-
Tablas Repaso Microbiologia
He publicado nuevos apuntes de 2º Microbiología: Tablas Repaso Microbiologia
apuntes
-
apuntes micro
He publicado nuevos apuntes de 2º Microbiología: apuntes micro
apuntes
-
ESQUEMAS PARCIAL 1
He publicado nuevos apuntes de 2º Microbiología: ESQUEMAS PARCIAL 1
apuntes
-
Resumen micro primera parte (temas 1-6)
Resúmenes de cada tema en dos caras
He publicado nuevos practicas de 2º Microbiología: GUION-practicas-MICRO.pdf
He publicado nuevos apuntes de 2º Microbiología: tema-2-microbiologia.pdf
He publicado nuevos apuntes de 2º Microbiología: TEMA-3-TECNICAS-MICROBIOLOGICAS.pdf